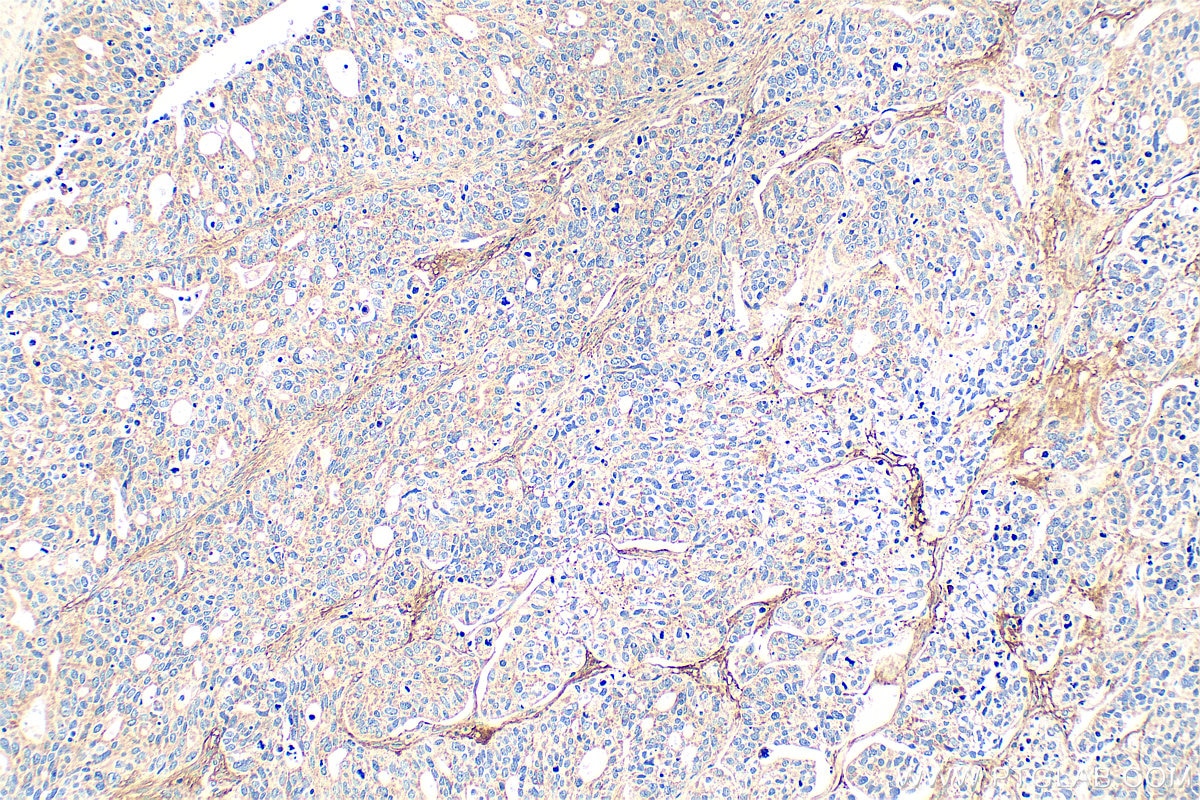
Immunohistochemical analysis of paraffin-embedded human ovary tumor tissue slide using 21129-1-AP (KIAA1199 / CEMIP antibody) at dilution of 1:200 (under 10x lens). Heat mediated antigen retrieval with Tris-EDTA buffer (pH 9.0). Immunohistochemistry (IHC) staining of human ovary tumor tissue using KIAA1199 / CEMIP Polyclonal antibody (21129-1-AP)
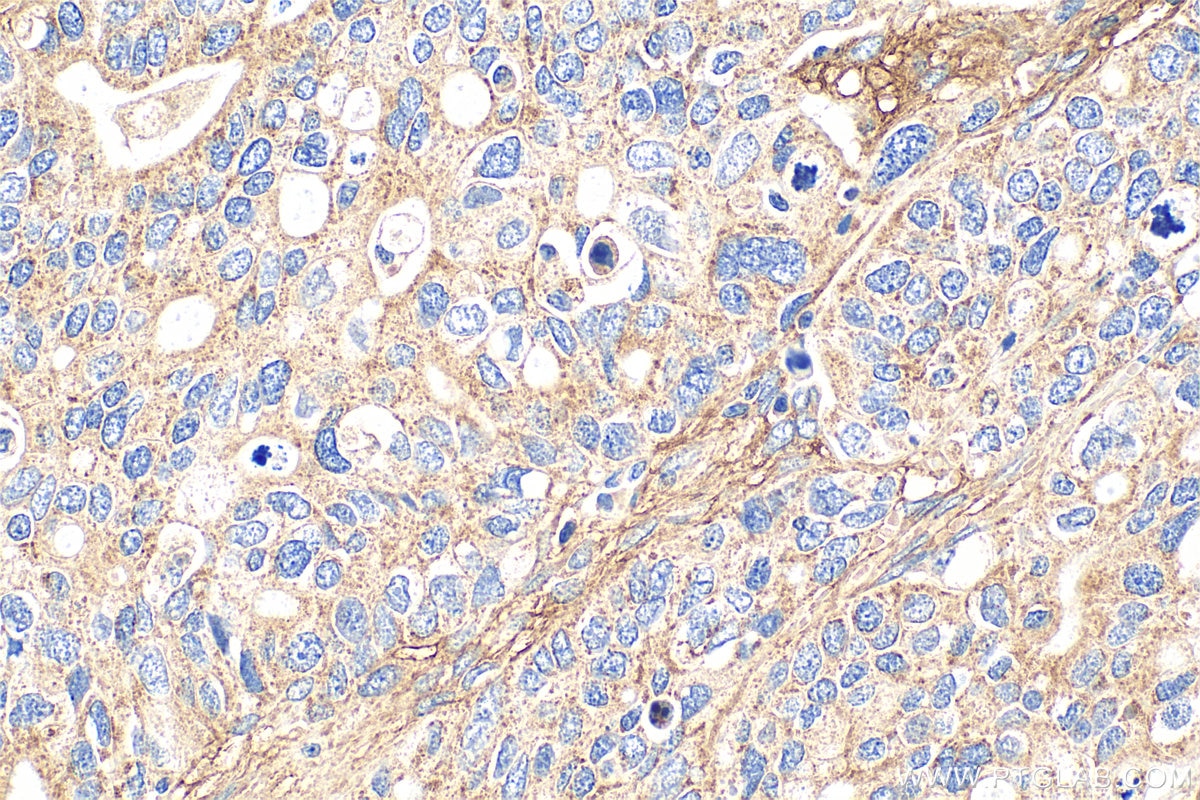
Immunohistochemical analysis of paraffin-embedded human ovary tumor tissue slide using 21129-1-AP (KIAA1199 / CEMIP antibody) at dilution of 1:200 (under 40x lens). Heat mediated antigen retrieval with Tris-EDTA buffer (pH 9.0). Immunohistochemistry (IHC) staining of human ovary tumor tissue using KIAA1199 / CEMIP Polyclonal antibody (21129-1-AP)

Tested Applications
| Positive WB detected in | COLO 320 cells, SGC-7901 cells |
| Positive IHC detected in | human ovary tumor tissue, rat brain tissue Note: suggested antigen retrieval with TE buffer pH 9.0; (*) Alternatively, antigen retrieval may be performed with citrate buffer pH 6.0 |
Recommended dilution
| Application | Dilution |
|---|---|
| Western Blot (WB) | WB : 1:500-1:1000 |
| Immunohistochemistry (IHC) | IHC : 1:50-1:500 |
| It is recommended that this reagent should be titrated in each testing system to obtain optimal results. | |
| Sample-dependent, Check data in validation data gallery. | |
Published Applications
| KD/KO | See 18 publications below |
| WB | See 35 publications below |
| IHC | See 29 publications below |
| IF | See 9 publications below |
| IP | See 2 publications below |
| CoIP | See 2 publications below |
Product Information
21129-1-AP targets KIAA1199 / CEMIP in WB, IHC, IF, IP, CoIP, ELISA applications and shows reactivity with human, rat samples.
| Tested Reactivity | human, rat |
| Cited Reactivity | human, mouse, rat, marmoset |
| Host / Isotype | Rabbit / IgG |
| Class | Polyclonal |
| Type | Antibody |
| Immunogen |
CatNo: Ag15527 Product name: Recombinant human KIAA1199 protein Source: e coli.-derived, PGEX-4T Tag: GST Domain: 31-386 aa of BC020256 Sequence: TVAAGCPDQSPELQPWNPGHDQDHHVHIGQGKTLLLTSSATVYSIHISEGGKLVIKDHDEPIVLRTRHILIDNGGELHAGSALCPFQGNFTIILYGRADEGIQPDPYYGLKYIGVGKGGALELHGQKKLSWTFLNKTLHPGGMAEGGYFFERSWGHRGVIVHVIDPKSGTVIHSDRFDTYRSKKESERLVQYLNAVPDGRILSVAVNDEGSRNLDDMARKAMTKLGSKHFLHLGFRHPWSFLTVKGNPSSSVEDHIEYHGHRGSAAARVFKLFQTEHGEYFNVSLSSEWVQDVEWTEWFDHDKVSQTKGGEKISDLWKAHPGKICNRPIDIQATTMDGVNLSTEVVYKKGQDYRFA Predict reactive species |
| Full Name | KIAA1199 / CEMIP |
| Calculated Molecular Weight | 1361 aa, 153 kDa |
| Observed Molecular Weight | 150 kDa |
| GenBank Accession Number | BC020256 |
| Gene Symbol | KIAA1199 |
| Gene ID (NCBI) | 57214 |
| RRID | AB_10695771 |
| Conjugate | Unconjugated |
| Form | Liquid |
| Purification Method | Antigen affinity purification |
| UNIPROT ID | Q8WUJ3 |
| Storage Buffer | PBS with 0.02% sodium azide and 50% glycerol, pH 7.3. |
| Storage Conditions | Store at -20°C. Stable for one year after shipment. Aliquoting is unnecessary for -20oC storage. 20ul sizes contain 0.1% BSA. |
Background Information
KIAA1199, also known as CEMIP, was first discovered as an inner-ear protein whose genetic mutations were linked to nonsyndromic hearing loss. KIAA1199 is involved in hyaluronan degradation. Studies have shown that KIAA1199 is overexpressed in many types of cancers, suggesting a critical role of KIAA1199 in cancer progression.
Protocols
| Product Specific Protocols | |
|---|---|
| IHC protocol for KIAA1199 / CEMIP antibody 21129-1-AP | Download protocol |
| WB protocol for KIAA1199 / CEMIP antibody 21129-1-AP | Download protocol |
| Standard Protocols | |
|---|---|
| Click here to view our Standard Protocols |
Publications
| Species | Application | Title |
|---|---|---|
Nat Commun TREX tetramer disruption alters RNA processing necessary for corticogenesis in THOC6 Intellectual Disability Syndrome | ||
Sci Adv Single-cell analysis of human basal cell carcinoma reveals novel regulators of tumor growth and the tumor microenvironment. | ||
Am J Hum Genet Altered regulation of DPF3, a member of the SWI/SNF complexes, underlies the 14q24 renal cancer susceptibility locus.
| ||
Theranostics Functional Genomic mRNA Profiling of Colorectal Adenomas: Identification and in vivo Validation of CD44 and Splice Variant CD44v6 as Molecular Imaging Targets. | ||
Acta Pharmacol Sin Adaptor protein CEMIP reduces the chemosensitivity of small cell lung cancer via activation of an SRC-YAP oncogenic module
| ||
Cell Rep Cochlear Cell Modeling Using Disease-Specific iPSCs Unveils a Degenerative Phenotype and Suggests Treatments for Congenital Progressive Hearing Loss. |
Reviews
The reviews below have been submitted by verified Proteintech customers who received an incentive for providing their feedback.
FH DAN (Verified Customer) (06-10-2022) |
|